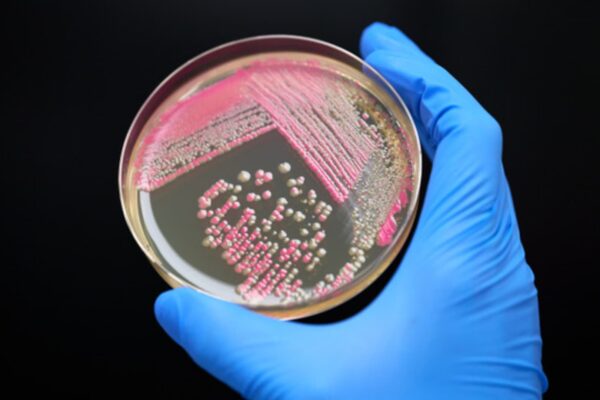
Debut Biotech partners with Image Skincare for personalized beauty

ServiceNow CEO says AI companies aren’t threatening enterprise software
ServiceNow CEO Bill McDermott pushed back against the idea that artificial intelligence technology will make enterprise software redundant in a Wednesday interview with CNBC’s Jim Cramer. “We realize the world needs access to the great hyperscalers, and so we integrated with all three of them. So that’s a cooperative,” McDermott said. “The world’s going to…